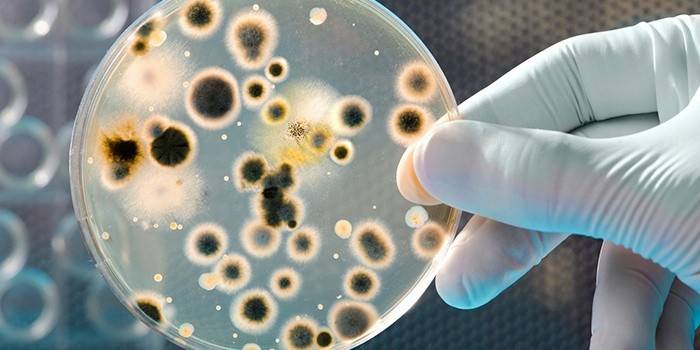

Ureaplasmosis u kobiet
Choroby zakaźne u kobiet nie są rzadkie. Zwłaszcza we współczesnym świecie. Takie problemy obejmują ureaplasmosis u kobiet. Zakażenie Ureaplasma, co to jest, jakie są objawy i przyczyny, jak leczyć chorobę? Ureaplasmosis odnosi się do infekcji zapalnych występujących w układzie moczowo-płciowym. Czynnikami sprawczymi są drobnoustroje Gram-ujemne. Ureaplasma w medycynie prawie nigdy nie występuje jako niezależna dolegliwość, często jest wykrywana wraz z chlamydią i mykoplazmą (mykoplazmozą).
Co to jest ureaplasma parvum i urealitikum
Lekarze rozróżniają kilka rodzajów mikroorganizmów, które powodują znaczne zapalenie narządów żeńskich. Jeden z gatunków ma nazwę ureaplasma urealitikum (ureaplasma urealyticum). „Proces” tego gatunku to ureaplasma parvum (ureaplasma parvum). Lekarze nie dzielą ureaplasmosis urealiticum u kobiet i ich gałęzi parwum. Zwalczają te drobnoustroje za pomocą identycznych leków, charakteryzują się tymi samymi znakami, powikłaniami. W większości przypadków gatunki ureaplasma są grupowane w grupę gatunków ureaplasma.
Przyczyny choroby
Pozytywna gleba dla reprodukcji ureaplasmosis u kobiet i rozprzestrzeniania się drobnoustrojów w układzie moczowo-płciowym opiera się na następujących przyczynach:
- znaczące zmiany w układzie odpornościowym (silne osłabienie układu odpornościowego);
- rodzenie dzieci lub przerwanie ciąży;
- przewlekłe choroby zakaźne;
- zaburzenia hormonalne podczas menstruacji.
Główne objawy u kobiet
Objawy ureaplasmy w ciele kobiety są czasami wykrywane przypadkowo, poprzez diagnozę innej choroby. W innych okolicznościach objawy ureaplasmosis są rozpoznawane bez problemów. Oto niektóre z nich:
- Jeśli wydzielina z pochwy jest normalna, są one bezbarwne i nie pachną. Wyładowania koloru żółtego, o nieprzyjemnym zapachu, sygnalizują obecność ureaplasmy.
- Ból, znaczny dyskomfort w pochwie podczas seksu i pod koniec stosunku są częstymi objawami ureaplasmosis.
- Ureaplasmas mogą pojawiać się jako cięcia w dolnej części brzucha (wskazują na prawdopodobne zakażenie przydatków i macicy).
- Jeśli zakażenie ureaplasmosis ma charakter ustno-płciowy, wówczas występują objawy charakterystyczne dla dławicy piersiowej (płytka nazębna na migdałkach, ból gardła).
- Zwiększone oddawanie moczu, powodujące pieczenie, dyskomfort w cewce moczowej.
Jeśli ureaplasma nie powoduje dyskomfortu, bólu, nadal konieczne jest jego wyeliminowanie. Terminowe skontaktowanie się ze specjalistą nie pozwoli na rozwój choroby zakaźnej, pomoże uniknąć powikłań, w tym przewlekłej ureaplasmosis (wymaga długiej i skomplikowanej terapii). Konieczne jest ciągłe monitorowanie stanu zdrowia.
Metody diagnostyczne
Rozpoznanie ureaplasmosis w ciele przeprowadza się na kilka sposobów. Pacjent musi przejść serię testów w celu potwierdzenia lub odmowy obecności zakażenia ureaplazmowego u ludzi. Lekarze stosują cztery podstawowe techniki do wykrywania ureaplasmy w ciele kobiety:

- Najdokładniejszym sposobem ustalenia ureaplasmosis jest analiza PCR. Gdy ureaplasma zostanie znaleziona przy użyciu popularnej techniki, diagnoza jest kontynuowana. To prawda, że ta metoda nie jest używana do testowania wyników leczenia ureaplasmosis urealyticum u kobiet.
- Inną dobrą metodą obliczania ureaplasmy jest metoda serologiczna, która wykrywa przeciwciała przeciwko strukturom szkodliwych drobnoustrojów.
- Aby określić liczbę czynników wywołujących chorobę ureaplazmową, stosuje się siew bakteriologiczny analizy.
- Kolejną i ostatnią metodą diagnozowania ureaplasmosis jest UIF (bezpośrednia immunofluorescencja) i ELISA (analiza immunofluorescencyjna).
Jak przeprowadzić analizę ureaplasma
Analiza ureaplasma przeprowadzana jest w następujący sposób. Lekarz pobiera skrobanie z łuków pochwy, kanału szyjki macicy lub błony śluzowej cewki moczowej kobiety. Okresowo krew i mocz są pobierane od pacjenta w celu wykrycia ureaplasma. Kilka prostych, ale ważnych zasad przygotowywania się do testów do diagnozy ureaplasmosis:

- przerwanie przebiegu leków z grupy przeciwbakteryjnej na dwa do trzech tygodni przed testem;
- podczas pobierania materiału biologicznego z cewki moczowej lekarze radzą, aby nie oddawać moczu przez 2 godziny przed skrobaniem;
- gdy kobieta ma miesiączkę, nie wykonuje się testów na ureaplasmosis;
- krew należy oddawać wyłącznie na pusty żołądek, w przeciwnym razie wyniki badań ureaplasma mogą być błędne;
- w przypadku oddania moczu lepiej jest zebrać część, która znajdowała się w moczniku przez co najmniej 6-7 godzin.
Jak leczyć ureaplasmosis u kobiet
Zakażenie Ureaplasma odnosi się do takich chorób, które prawie nie dają szansy na wyleczenie na zawsze. Każda kobieta rodzi się z pewną mikroflorą, która nie zmienia się przez całe życie. Aby pozbyć się ureaplasmy, musisz zminimalizować liczbę pasożytów o warunkowym „statusie”, po prostu niszcząc większość tych mikroorganizmów.
Schemat leczenia uzależnień
Środki terapeutyczne w celu wyeliminowania ureaplasmosis mogą mieć inny charakter. Główną grupą leków leczniczych są tabletki przeciwbakteryjne, czopki. Leki na ureaplasma są podzielone na trzy grupy:
- linkozamidy (tabletki „Linkomycyna”, „Dalacyna”);
- makrolidy („erytromycyna”, „Rulid”, „Sumamed”);
- tetracyklidy (doksycyklina, tetracyklina w tabletkach).

Proces terapeutyczny ureaplasmosis za pomocą leków przeciwbakteryjnych dzieli się na dwa typy: tabletki antybiotykowe (terapia ogólnoustrojowa) i czopki dopochwowe (terapia lokalna). Osiągnięcie skutecznego wyniku jest możliwe dzięki połączeniu tych technik. Leki terapeutyczne:
- Najskuteczniejsze czopki ureaplasma dla kobiet to „Hexicon”, „Genferon”.
- Nadal do leczenia infekcji ureaplasma za pomocą leków wzmacniających układ odpornościowy - „Lizozym”, „Timalina”. Gardnerella (drobnoustrój powodujący dysbiozę w pochwie) jest leczony identycznymi lekami.
Schemat leczenia ureaplasma u kobiet
- Lekarz przepisuje środki przeciwdrobnoustrojowe, immunostymulujące.
- Indywidualna mikroflora jelit, pochwy, zniszczona przez ureaplasma, zostaje przywrócona. W tym celu pacjent powinien spożywać korzystne bakterie mlekowe i bifidobakterie.
- Cały okres pozbywania się infekcji ureaplazmowej musi powstrzymywać się od aktywności seksualnej.
- Lekarz przepisuje miejscowe leczenie za pomocą doodbytniczych czopków dopochwowych.
- Przygotowana jest specjalna dieta, która wyklucza alkohol, tłuszcze, smażone, przyprawy, sosy.
Skuteczne środki ludowe
Ureaplasmosis można czasem wyleczyć za pomocą tradycyjnej medycyny. Składniki do przygotowania domowych leków najlepiej kupić w aptece miejskiej. Oferujemy kilka skutecznych przepisów ludowych na walkę z ureaplasmą w kobiecym ciele:

- Pomożemy nam pokonać ureaplasma z korzeniami lukrecji, leuzeów, grosza, sukcesji, szyszek olszy i kwiatów rumianku. Wlać 1 łyżkę stołową każdego składnika do pojemnika. Otrzymany wynik należy ostrożnie posiekać, wymieszać. Szklankę wrzącej wody zalać jedną łyżką kolekcji, nalegamy 8-10 godzin. Nalewkę należy spożywać trzy razy dziennie przed posiłkami, 1/3 szklanki.
- Do przygotowania kolejnego krajowego leku z ureaplasmosis bierzemy tymianek, ledum, krwawnik pospolity, sznurek, pąki brzozy, korzenie leuze, krwotok. Zmielimy wszystkie składniki, wymieszamy, biorąc je w tej samej ilości (1 łyżka. L). Zalej jedną łyżeczkę mieszanki ziołowej szklanką gorącej wody. Nalegamy około 9-10 godzin. Lek należy pić pół szklanki przed posiłkiem dwa razy dziennie.
Co leczy ureaplasma u kobiet w ciąży?
W okresie ciąży ciało kobiety jest osłabione, więc infekcja łatwo przenika do wnętrza. Terminowe wykrycie ureaplasmy u kobiety w ciąży jest kluczem do skutecznego leczenia. Jeśli zastosujesz się do zaleceń ginekologa, w 96% przypadków ureaplasmosis można pozbyć się infekcji bez konsekwencji. Proces gojenia rozpoczyna się w drugim trymestrze ciąży, kiedy płód nabył już kosmówkę (przyszłe łożysko). Ureaplasma podczas ciąży jest często niszczona przez lek „Josamycin”. Ponadto lekarz przepisuje witaminy, które wzmacniają układ odpornościowy.
Zapobieganie chorobom
Środki zapobiegawcze w celu zapobiegania ureaplasmosis u kobiet:
- ciągłe utrzymywanie odporności w dobrym stanie (stwardnienie, witaminy, zdrowe odżywianie);
- zastosowanie barierowych metod ochrony przed ureaplasmosis;
- odmowa przypadkowej intymności z różnymi partnerami;
- ścisłe przestrzeganie zasad higieny intymnej;
- ureaplasmosis należy leczyć nie tylko u kobiet, ale także u stałego partnera seksualnego.
Wideo na temat zakażenia ureaplasma u kobiet
Jeśli chcesz dowiedzieć się więcej informacji o infekcji ureaplasmic u kobiet, możesz obejrzeć poniższe klipy wideo i zdjęcia. Z przydatnego filmu dowiesz się, co stanowi ureaplasmosis, usłyszysz o objawach choroby, sposobach dostania się do organizmu. Lekarz powie ci, jak leczyć ureaplasma, jakie środki zapobiegawcze przeciw infekcji ureaplazmowej istnieją obecnie. To ochroni cię przed niebezpieczną dolegliwością.